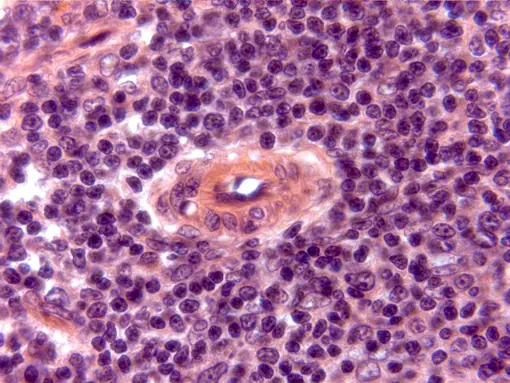
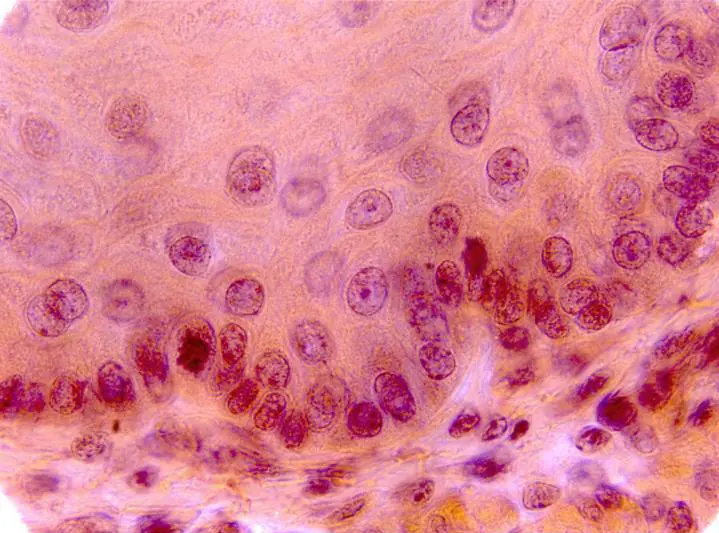

dijo:La Histología es la ciencia que estudia todo lo referente a los tejidos orgánicos: su estructura microscópica, su desarrollo y sus funciones. La histología se identifica a veces con lo que se ha llamado anatomía microscópica, pues su estudio no se detiene en los tejidos, sino que va más allá, observando también las células interiormente y otros corpúsculos, relacionándose con la bioquímica y la citología.
dijo:[Megapost] Histologia Humana Pte. I: http://www.taringa.net/posts/ciencia-educacion/12301761/_Megapost_-Histologia-Humana-Pte_-I.html
dijo:
dijo:Sección transversal de una arteria elástica, teñida con hematoxilina/eosina y observada con el objetivo de 10x. Se distinguen las tres capas que la integran, de fuera a dentro: adventicia, media e íntima, ésta última en contacto con la luz del órgano.
dijo:Con el objetivo de 40x se distinguen las tres capas: adventicia, media e íntima (ésta última en torno a la luz) de la arteria. En otra microfotografía se aprecia un detalle de las dos primeras (rojo)
dijo:Con el objetivo de 100x se distinguen con detalle las capas íntima (en contacto con la luz) y media de la arteria. La primera, constituida por un endotelio, descansa sobre una lámina elástica. Por debajo (hacia el exterior del órgano) se localiza la capa media, formada por numerosas láminas elásticas, fibras musculares lisas y fibroblastos
dijo:
dijo:Reconstrucción fotográfica de parte de una sección de bazo, teñida con hematoxilina/eosina y observada con el objetivo de 10x. A este aumento se aprecia la cápsula formada por conjuntivo denso, de la cual parten trabéculas hacia el interior del órgano, además del parénquima esplénico. Éste lo integran dos zonas, denominadas pulpa blanca y pulpa roja, con un componente mayoritario linfocítico la primera y gran cantidad de eritrocitos la segunda. En otras microfotografías se ofrecen detalles a mayor aumento de algunas áreas (zonas encuadradas en azul y en rojo)
dijo:(Zona encuadrada en azul)Con el objetivo de 40x se observa un detalle de la superficie del órgano y parte de la pulpa del mismo. Son visibles la cápsula conjuntiva y una de las trabéculas que parten de ella, así como parte de la pulpa blanca y roja, más internamente localizadas. En otras microfotografías se aprecian detalles a mayor aumento de cada una de estas estructuras (zonas encuadradas en azul, rojo y amarillo)
dijo:(Azul) Con el objetivo de 100x se muestra el detalle de la cápsula esplénica, recubierta externamente por endotelio y en la que se distinguen núcleos de fibrocitos y abundante material fibrilar. Internamente a la cápsula se localiza parte del parénquima esplénico, pudiendo observarse uno de los sinusoides venosos
dijo:(Rojo) Con el objetivo de 100x se observa un detalle de una de las trabéculas, formada por tejido conjuntivo denso, distinguiéndose en ella, tanto fibras, como núcleos de las células integrantes. A ambos lados de la trabécula son visibles numerosos linfocitos, con sus núcleos teñidos de azul, formando parte de la pulpa blanca
dijo:(Amarillo) Con el objetivo de 100x se observa el detalle de uno de los sinusoides venosos que integran la pulpa roja. Se distingue algún núcleo del endotelio que lo reviste, así como los núcleos de células de la sangre en su interior. Alrededor aparece parte de la pulpa roja, siendo visibles numerosos hematíes
dijo:(Zona encuadrada en rojo)Con el objetivo de 40x se observa uno de los corpúsculos de Malpighi, en el cual se distingue la arteria central, rodeada del centro germinativo, con una marcada densidad de linfocitos y una zona marginal de transición con la pulpa roja a la izquierda, de menor densidad linfocítica. Más externamente se aprecia parte de la citada pulpa roja. En otra microfotografía se observa un detalle a mayor aumento de la parte central del corpúsculo (rojo)
dijo:Con el objetivo de 100x se observa el detalle de uno de los corpúsculos de Malpighi, en el cual se distingue la pared de la arteria central, rodeada del centro germinativo, con una marcada densidad de linfocitos
dijo:
dijo:En esta sección, teñida con violeta de cresilo y obtenida con el objetivo de 4x, se distingue la corteza cerebelosa, formada por sustancia gris, muy replegada, formando laminillas y bajo ella la sustancia blanca. A su vez, en la sustancia gris, se aprecian las capas granular y molecular. En otra microfotografía se muestra la corteza a mayor aumento (rojo)
dijo:Se aprecia aquí, con el objetivo de 10x, parte de la sustancia gris, donde se insinúan los somas neuronales, dispuestos zonadamente en una capa granular y otra molecular perfectamente identificables, así como la sustancia blanca. En otra microfotografía se observan a mayor aumento las diferentes capas neuronales (rojo)
dijo:Pueden apreciarse aquí, con el objetivo de 40x, las tres capas de células nerviosas que integran la corteza cerebelosa: capa molecular, capa de células de Purkinje y capa granular. Nótese la diferente densidad y tamaño de las neuronas de cada una, destacando los grandes somas de las células de Purkinje, apreciables a mayor aumento en otra microfotografía (rojo)
dijo:En esta microfotografía, obtenida con el objetivo de 100x, se observan dos grandes células de Purkinje, algunos núcleos de células de la capa molecular y una gran densidad de neuronas en la capa granular
dijo:
dijo:Corte semifino transversal teñido con azul de toluidina. En esta microfotografía, tomada con el objetivo de 4x, se observan las diferentes capas que integran la pared duodenal: muscular, submucosa y mucosa que se prolonga hacia la luz del órgano mediante repliegues o vellosidades intestinales. En otras microfotografías aparecen detalles a mayor aumento de estas vellosidades, así como de cada una de las capas citadas (zonas encuadradas en azul y rojo)
dijo:(Zona encuadrada en azul) Aspecto de tres vellosidades con el objetivo de 40x, rodeadas por la luz del órgano. Cada una de ellas está tapizada por un epitelio prismático simple y una zona interna de naturaleza conjuntiva. Ambas pueden observarse a mayor aumento en otra microfotografía (recuadro en rojo)
dijo:Detalle con el objetivo de 100x de las vellosidades intestinales, rodeadas por la luz intestinal. En cada una de ellas se aprecia un epitelio prismático simple, cuyas células muestran un núcleo ovalado y un polo apical, en contacto con la luz, provisto de microvellosidades. Entre las células epiteliales aparecen otras secretoras de tipo caliciforme. El interior de cada vellosidad está ocupado por tejido conjuntivo rico en vasos sanguíneos y linfáticos
dijo:(Zona encuadrada en rojo) Aspecto con el objetivo de 40x de la pared duodenal, donde pueden apreciarse la capa muscular, formada a su vez por la túnica externa longitudinal y la interna circular. Hacia el interior se observan la submucosa conjuntiva, rica en fibras colágenas y parte de la mucosa, correspondiente a las vellosidades. En otra microfotografía puede verse un detalle de la pared muscular (rojo)
dijo:Detalle con el objetivo de 100x de la capa muscular. Se observa la más externa, formada por fibras musculares lisas, dispuestas longitudinalmente y la más interna, con fibras dispuestas en sentido circular. En ambas se aprecian con claridad los núcleos de las fibras integrantes. Aparece también parte de la submucosa conjuntiva, conteniendo un ganglio nervioso perteneciente al plexo de Meissner en el que se distinguen algunas neuronas por su prominente núcleo.
dijo:
dijo:Sección transversal completa de esófago, teñida con hematoxilina y eosina y obtenida con el objetivo de 4x. En otras microfotografías se muestran detalles a mayor aumento de las diferentes capas que lo forman (zona encuadrada en azul), así como la muscular (zona encuadrada en rojo)
dijo:(Zona encuadrada en rojo) Sección transversal de esófago, obtenida con el objetivo de 40x, observándose la capa muscular, integrada a su vez por una túnica externa y otra interna, cuyas fibras se orientan en sentido longitudinal y circular, respectivamente. La musculatura que forma esta capa es de tipo liso, como en el resto del tubo digestivo, salvo en esta región concreta del esófago (tercio superior) que es de tipo estriado, como puede aquí apreciarse
dijo:(Zona encuadrada en azul) Sección transversal de esófago, obtenida con el objetivo de 10x. En el centro se aprecia la luz del órgano y desde aquí hacia el exterior, la mucosa, formada a su vez por el epitelio, directamente en contacto con la luz y muscular de la mucosa. Más externamente, la submucosa y la túnica muscular. En otra microfotografía (azul) se aprecian con mayor detalle estas capas
dijo:Sección transversal de esófago, obtenida con el objetivo de 40x, observándose el detalle de algunas de las capas que lo forman. En contacto con la luz del órgano se encuentra el epitelio, de tipo plano estratificado, mostrando los núcleos de sus células integrantes en color azul. Bajo este se distingue la lámina propia, formada por tejido conjuntivo, la capa muscular de la mucosa, integrada por fibras musculares lisas cortadas transversalmente y la submucosa, también a base de tejido conjuntivo. En otra microfotografía se aprecia un detalle del epitelio (azul)
dijo:Sección transversal de esófago, obtenida con el objetivo de 100x, observándose el detalle del epitelio plano estratificado, concretamente la capa basal o germinativa del mismo mostrando claramente los núcleos de las células, algunas en mitosis. Bajo ella se aprecia parte de la lámina propia
dijo:
dijo:Aspecto de la sección transversal de la pared gástrica, teñida con hematoxilina/eosina y observada con el objetivo de 4x. Se aprecian las diferentes capas que la forman, desde la luz interna, hasta el exterior: mucosa, muscular de la mucosa, submucosa y muscular. En otras microfotografías se observan detalles a mayor aumento de diferentes zonas (recuadros en color)
dijo:(Zona encuadrada en rojo) Aspecto de la sección transversal de la pared gástrica, observada con el objetivo de 10x. Se aprecian las capas adventicia (más externa) y muscular, esta última integrada por una lámina externa y otra interna. Entre ambas capas musculares se sitúa el plexo nervioso de Auerbach, formado por numerosos ganglios, en los cuales se distinguen sus neuronas. En la adventicia son visibles algunos vasos sanguíneos
dijo:(Zona encuadrada en amarillo) Aspecto de un detalle de la sección transversal de la pared gástrica, observada con el objetivo de 100x, correspondiente a una zona de la mucosa. Se aprecian las células integrantes de las glándulas tubulares: parietales y principales
dijo:(Zona encuadrada en amarillo) Aspecto de la sección transversal de la pared gástrica, observada con el objetivo de 10x. Desde el exterior al interior y por este orden, se aprecian la túnica muscular interna, submucosa, muscular de la mucosa y mucosa. Son también visibles los repliegues de ésta última, visibles a mayor aumento en otra microfotografía (recuadro en azul). Igualmente puede observarse un detalle de la mucosa y muscular de la mucosa en otra microfotografía (recuadro en rojo)
dijo:
dijo:Reconstrucción fotográfica de parte de una sección de ganglio linfático, teñida con hematoxilina/eosina y observada con el objetivo de 10x. De fuera a dentro se distingue una cápsula de naturaleza conjuntiva que emite trabéculas hacia el interior, bajo la que se localiza la corteza, formada por folículos linfáticos y más internamente la médula, con abundantes vasos, formada por cordones y senos medulares. Tanto los folículos, como los cordones medulares tienen un aspecto más denso, coloreado de azul, por la presencia en ellos de abundantes linfocitos. En otras microfotografías se ofrecen detalles a mayores aumentos de cada estructura (zonas encuadradas en distintos colores)
dijo:(Zona encuadrada en amarillo) Aspecto de la zona próxima a la cápsula ganglionar, observada con el objetivo de 40x. Bajo la citada estructura, aparece una zona más láxamente dispuesta: el seno subcapsular e inmediatamente por debajo, parte de uno de los folículos linfáticos, con numerosos linfocitos de núcleos teñidos en azul.
dijo:(Zona encuadrada en azul) Aspecto, con el objetivo de 40x de los senos medulares, constituidos en su mayor parte por tejido conjuntivo reticular, con los núcleos de las células reticulares en color azul. Destacan además dos cordones medulares, integrados por gran número de linfocitos, distinguibles aquí por estar teñidos de azul. En otra microfotografía se aprecia el área encuadrada en rojo a mayor aumento
dijo:(Zona encuadrada en rojo) Reconstrucción fotográfica, con el objetivo de 40x, de la corteza superficial, mostrando un nódulo o folículo linfático secundario bajo la cápsula del ganglio. También aparecen dos senos, uno subcapsular y parte del medular, formados por conectivo reticular, más laxamente dispuesto que el resto. El folículo consta de una zona periférica o corona, formada por tejido linfoide densamente dispuesto y de otra central, más clara: el centro germinativo. A un lado del folículo se observa un vaso de endotelio alto, típico de los ganglios linfáticos.
dijo:(Zona encuadrada en verde) Detalle, con el objetivo de 100x, de una trabécula de conjuntivo denso que, procedente de la cápsula del ganglio, llega al interior de la corteza, distinguiéndose en ella los núcleos alargados de las células conjuntivas, de color azul, junto con numerosas fibras de colágeno teñidas de rosa por la eosina. Acompañando a la trabécula se observa un seno cortical, más laxamente dispuesto, con numerosos núcleos de células reticulares. Alrededor de la trabécula se dispone abundante tejido linfoide, perteneciente a los folículos localizados en la corteza del ganglio
dijo:
dijo:Corte semifino teñido con azul de toluidina, observado con el objetivo de 10x. Se aprecian los diferentes integrantes de la glándula en forma de acinos serosos (teñidos de azul intenso) y mucosos (teñidos de rojo azulado), separados por finos septos de colágeno, además de los conductos excretores, rodeados por tejido conectivo. En otras microfotografías pueden verse a mayores aumentos detalles de los conductos excretores (recuadro en rojo) y zonas acinares (recuadros en azul y verde)
dijo:(Zona encuadrada en rojo) Aspecto con objetivo de 40x de una zona ocupada por un conducto excretor cortado transversalmente en distintas secciones. En cada una de ellas se aprecia su luz, así como el revestimiento epitelial cuboideo con aparentes núcleos teñidos de azul. En torno a los conductos, aparece un tejido conectivo integrado por fibras de colágeno teñidas de azul claro y numerosos núcleos de los fibrocitos, en azul más oscuro. Alrededor de la zona de conectivo aparecen acinos serosos teñidos en azul y mucosos en rojo
dijo:(Zona encuadrada en verde) Aspecto con objetivo de 40x de la parte acinar de la glándula, donde puede identificarse la red de septos de colágeno que separa los acinos serosos (teñidos en azul) de los mucosos (teñidos de rojo)
dijo:(Zona encuadrada en azul) Detalle con objetivo de 100x de la parte acinar de la glándula, donde pueden identificarse acinos serosos y mucosos, así como parte de la red de septos de colágeno que los separa. En los acinos son visibles los núcleos de las células secretoras, teñidos intensamente de azul en los mucosos y más pálidamente y en clara posición basal en los serosos. En estos últimos puede observarse igualmente el material segregado, en forma de pequeñas esferas de color azul
dijo:
dijo:Hueso compacto, observado con el objetivo de 10x. Se aprecian varios sistemas de Havers completos, así como numerosos conductos centrales de éstos, en sección transversal. Igualmente, aparecen gran cantidad de lagunas óseas. En otra microfotografía aparece uno de los sistemas de Havers (zona encuadrada en azul) a mayor aumento
dijo:Detalle con el objetivo de 40x de un sistema de Havers. Se observa el conducto central y las lagunas óseas en cuyo interior destacan los núcleos de los osteocitos en color azul. El conducto central y parte del sistema de Havers (zona encuadrada en verde) pueden observarse a mayor aumento en otra microfotografía
dijo:Detalle con el objetivo de 100x de un sistema de Havers, con su conducto central. En torno a éste, aparecen las laminillas óseas, dispuestas concéntricamente, destacando en su interior lagunas óseas y conductos calcóforos, que las comunican entre sí y con las lagunas

dijo:Aspecto con el objetivo de 10x de una sección de hueso esponjoso. Se aprecian las trabéculas óseas rodeadas de médula ósea. En otras microfotografías aparecen detalles de las trabéculas a mayores aumentos (zona encuadrada en verde)

dijo:Detalle con el objetivo de 40x de parte de una trabécula ósea y de la médula ósea circundante. En la trabécula son visibles los osteocitos, ocupando las correspondientes lagunas, tal como se aprecia en otra microfotografía a mayor aumento (zona encuadrada en rojo)

dijo:Aspecto con el objetivo de 100x de una de las trabéculas. Se aprecian algunas lagunas óseas con un osteocito de aspecto estrellado en el interior de cada una. Igualmente son visibles las laminillas óseas que constituyen cada trabécula, dispuestas de forma paralela
dijo:
dijo:Sección transversal de intestino delgado, teñida con hematoxilina y eosina y obtenida con el objetivo de 4x. A este pequeño aumento solo se distinguen con claridad la luz del órgano en el centro, la mucosa, la capa muscular y una delgada serosa en el exterior. En otras microfotografías se observan detalles a mayores aumentos (zonas encuadradas en rojo y en azul)
dijo:(Zona encuadrada en rojo) Aspecto de la túnica muscular y parte de la mucosa intestinal con el objetivo de 100x. Se observa la serosa con algunos de los núcleos de las células integrantes teñidos de azul. Debajo se encuentran las capas musculares externa e interna, formadas por fibras lisas, cuyos núcleos alargados se aprecian también claramente, sobre todo en la capa interna, al igual que el contorno longitudinal de las fibras de esta misma capa. Entre ambas capas aparece parte de un ganglio del plexo de Auerbach, con un elemento neuronal claramente identificable. Más hacia el interior puede verse la mucosa intestinal, destacando los núcleos teñidos de azul de sus células integrantes y la parte más profunda de las criptas de Lieberkühn con algunas células de Paneth
dijo:(zona encuadrada en azul) Aspecto de parte de la pared intestinal con el objetivo de 10x. Más externamente aparece una delgada serosa o adventicia, a continuación la túnica muscular, integrada a su vez por dos capas: una exterior y otra interior. Seguidamente la submucosa, formada por tejido conectivo y más internamente la mucosa, con una serie de vellosidades intestinales, un detalle de las cuales se puede observar en otra microfotografía (rojo). En el fondo de las vellosidades se sitúan las criptas de Lieberkühn, provistas de células secretoras, que pueden observarse a mayor aumento en otra microfotografía
dijo:Detalle de parte de una vellosidad intestinal con el objetivo de 40x. Se aprecia la luz intestinal, en contacto con la cual se encuentra el epitelio uniestratificado, formado por células prismáticas provistas de glucocálix y células secretoras caliciformes. Bajo el epitelio aparece la lámina propia, formada por tejido conjuntivo y vasos sanguíneos, no apreciables en este corte histológico. En otra microfotografía se aprecia el epitelio a mayor aumento (rojo)
dijo:Parte de dos vellosidades intestinales observadas con el objetivo de 100x. Se aprecia la luz intestinal y en contacto con ella el epitelio prismático, formado por células provistas de un aparente borde estriado, cuyos núcleos teñidos de azul son también visibles. También se incluyen en el epitelio células caliciformes encargadas de producir una secreción mucosa. Por debajo del epitelio se encuentra la lamina propia, formada por tejido conjuntivo laxo
dijo:
dijo:Aspecto de parte de una sección de intestino grueso, teñida con hematoxilina/eosina y observada con el objetivo de 4x. A este bajo aumento se llegan a distinguir las diferentes capas que integran su pared y que de fuera a dentro son: serosa, muscular, constituida a su vez por una túnica externa y otra interna, submucosa y finalmente mucosa, directamente en contacto con la luz del órgano. En otras microfotografías se muestran detalles a mayores aumentos de cada una de estas zonas (áreas encuadradas en rojo y en azul)
dijo:Reconstrucción fotográfica con el objetivo de 10x de la pared completa del intestino, pudiéndose apreciar con mayor detalle las capas que la forman, de fuera a dentro: serosa, muscular externa e interna, submucosa y mucosa, esta última con numerosas criptas de Lieberkühn, en contacto con la luz intestinal. Entre las dos túnicas musculares se sitúan una serie de ganglios nerviosos, pertenecientes al plexo de Auerbach. En otras microfotografías se muestran detalles a mayor aumento de la serosa y túnicas musculares, así como de la mucosa (zonas encuadradas en rojo, amarillo y azul, respectivamente)
dijo:(Zona encuadrada en rojo) Aspecto de la serosa y parte de la túnica muscular externa del intestino, con el objetivo de 40x. La serosa está formada por un epitelio (mesotelio) y conectivo subyacente, siendo visibles los núcleos de las células epiteliales y conectivas, además de algún vaso sanguíneo. Por debajo se observan las fibras musculares lisas de la túnica externa, cortadas transversalmente, con aparentes núcleos teñidos de azul
dijo:(Zona encuadrada en amarillo) Con el objetivo de 40x se aprecia parte de la túnica muscular interna del intestino, formada por fibras lisas dispuestas circularmente, por lo que aquí aparecen cortadas de forma longitudinal, mostrando cada una en el centro el núcleo teñido de azul por la hematoxilina
dijo:(Zona encuadrada en azul) Detalle, con el objetivo de 100x, del fondo de las criptas de Lieberkühn, distinguiéndose con claridad las células integrantes por sus núcleos teñidos de azul. En la parte superior de la microfotografía se aprecia parte de la capa muscular de la mucosa, formada por fibras lisas, de las cuales también son visibles sus núcleos
dijo:Link de la parte I arriva..
Muy pronto, la parte III